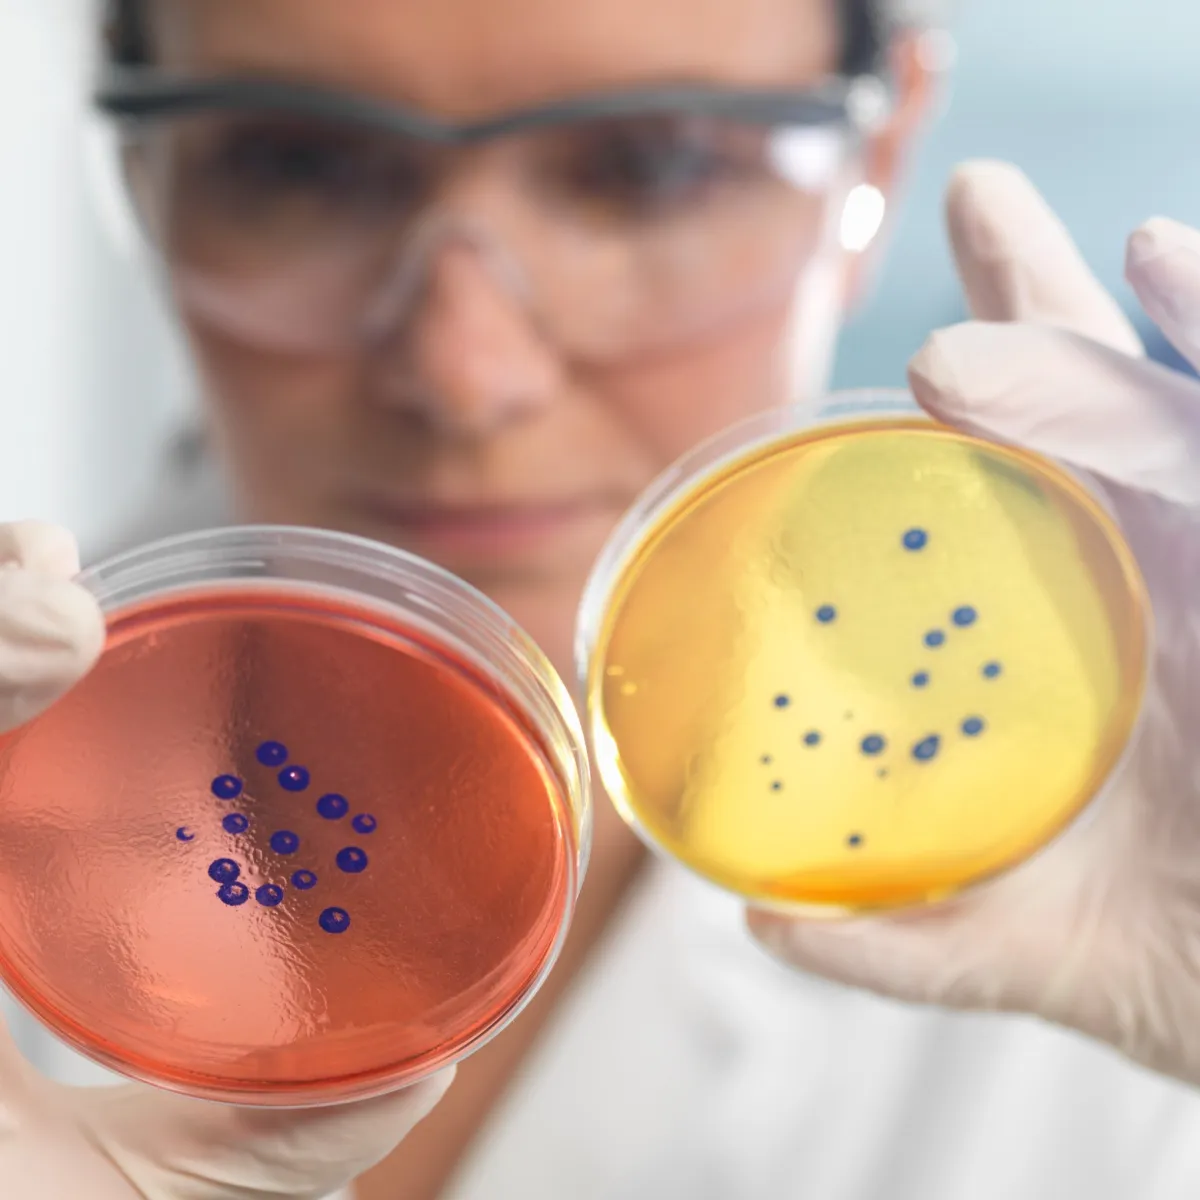
Laboratorio Clínico de Alta Especialidad y Rutina

Laboratorio Clínico de Alta Especialidad y Rutina
Laboratorio
Information
Contamos con un portafolio de más de 3,000 pruebas de diferentes Especialidades como:
o Hematología
o Coagulación
o Microbiología
o Hormonas
o Química Clínica
o Inmunología Especial
o Electroforesis
o Inmunofluorescencia
o Niveles de Drogas Terapéuticas
o Toxicología (niveles terapéuticos de medicamentos, pruebas de salud ocupacional, drogas de abuso, metales pesados)
o Bioquímica Especial
o Genética
o Biología Molecular
o Citometría de Flujo
o Citogenómica
o Tamizaje Neonatal
o Entre otras.
